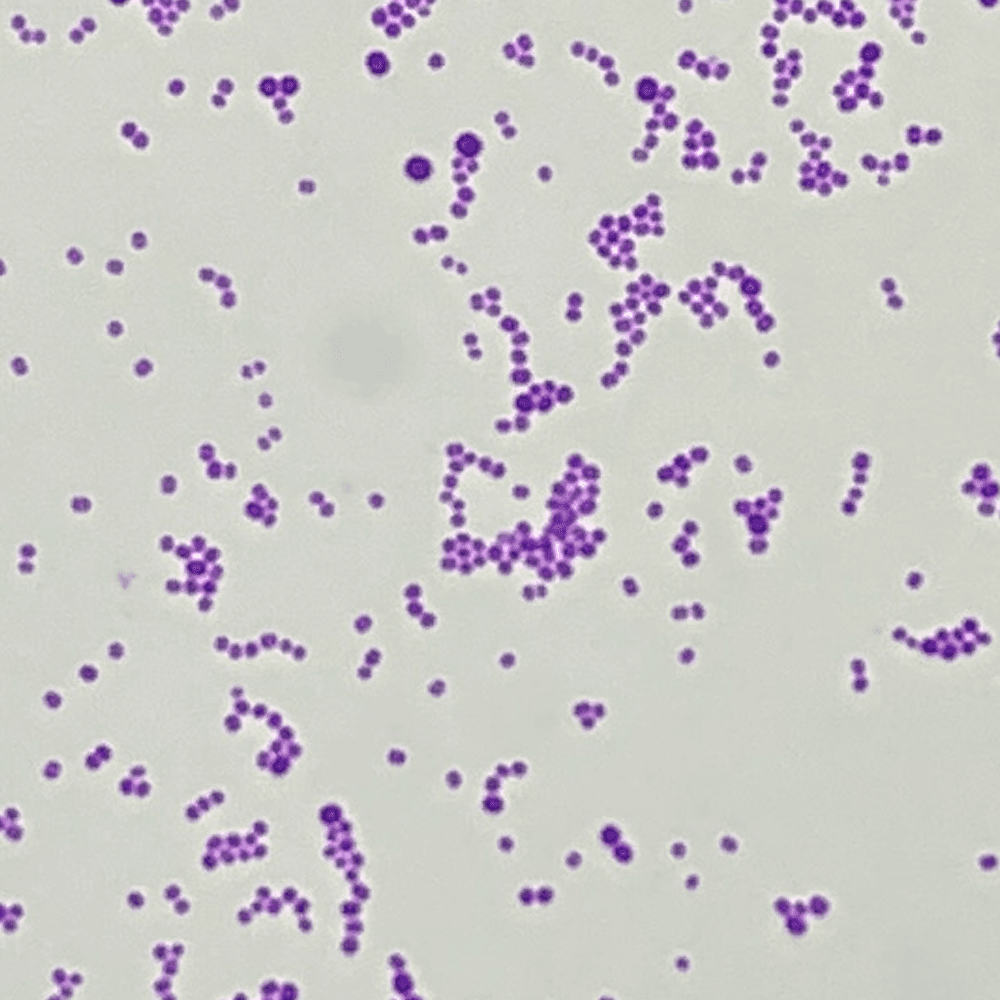
BITTE_1 - BiTTE® - Microbial Analysis BITTE_1 logo
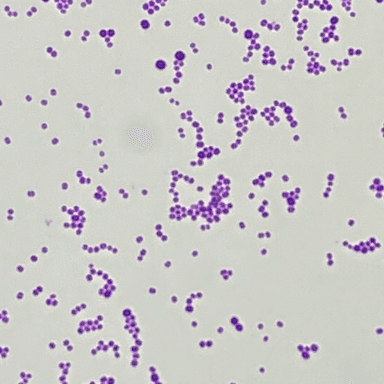
BITTE_1 - BiTTE® - Microbial Analysis BITTE_1 logo

ZOI_1
ZOI 1.0 - Zone of Inhibition - measurement
This app streamlines antimicrobial testing by automating the measurement of inhibition zones on Petri dishes. It analyzes images to determine areas where bacterial growth is inhibited, delivering fast and reliable results. Designed for microbiologists and researchers, the app enhances accuracy and efficiency in lab and research settings. Intended for Research Use Only (RUO).